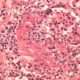
Poliangiitis microscópica

La granulomatosis eosinofílica con poliangeítis (GEP), antes conocida como el síndrome de Churg-Strauss, es una forma rara de vasculitis sistémica que afecta principalmente a pequeños vasos sanguíneos y se caracteriza por la inflamación de estos vasos en varias partes del cuerpo. Esta enfermedad está asociada a la presencia de anticuerpos anticitoplasma de neutrófilos (ANCA), que son autoanticuerpos dirigidos contra componentes de los neutrófilos, las células encargadas de la respuesta inmune frente a infecciones. La relación entre GEP y ANCA, especialmente los anticuerpos contra la mieloperoxidasa (anti-MPO), es importante en la etiología y diagnóstico de la enfermedad, aunque cabe destacar que la presencia de ANCA se encuentra en menos del 50% de los pacientes diagnosticados. Esta característica hace que la GEP, junto con otras vasculitis asociadas a ANCA, como la granulomatosis con poliangeítis y la poliangeítis microscópica, sea un grupo de enfermedades complejas en cuanto a su diagnóstico y manejo.
La relación de la GEP con los ANCA, y particularmente con los anticuerpos anti-MPO, se explica por la participación de los neutrófilos en la patogenia de la enfermedad. Los neutrófilos, en respuesta a diversas señales, liberan un conjunto de enzimas y mediadores inflamatorios que, cuando son dirigidos por estos anticuerpos, resultan en la inflamación de los vasos sanguíneos pequeños. Esta inflamación puede llevar a daño tisular, lo que explica muchas de las manifestaciones clínicas de la GEP. A pesar de esta asociación, no todos los pacientes con GEP presentan ANCA, lo que implica que otros mecanismos inmunológicos también pueden ser responsables de la patología en algunos casos.
Manifestaciones clínicas
Desde el punto de vista clínico, la GEP se distingue por una serie de manifestaciones que afectan a múltiples sistemas orgánicos, lo que refleja la naturaleza sistémica de la vasculitis. Una de las características más notorias es la eosinofilia periférica, que se refiere al aumento en el número de eosinófilos, un tipo de glóbulo blanco involucrado en la respuesta inmune frente a parásitos y en procesos alérgicos. La eosinofilia se asocia con la inflamación y la lesión tisular, y es un hallazgo frecuente en los pacientes con GEP.
La sinusitis crónica con poliposis nasal es otro hallazgo distintivo en esta enfermedad, y puede estar asociada con síntomas como congestión nasal, secreción mucosa espesa y obstrucción de las vías respiratorias superiores. Esta sinusitis puede ser de difícil tratamiento y puede requerir intervención quirúrgica en algunos casos para la extracción de los pólipos nasales.
El asma es otro componente fundamental de la GEP y se presenta en la mayoría de los pacientes. Esta condición se caracteriza por una inflamación crónica de las vías respiratorias, lo que resulta en dificultad respiratoria, sibilancias y tos. El asma en la GEP suele ser más grave y resistente a los tratamientos convencionales, ya que se encuentra relacionada con la alteración de la respuesta inmune.
Los infiltrados pulmonares, que se observan en los estudios de imagen, son comunes en los pacientes con GEP. Estos infiltrados se deben a la inflamación y al daño de los vasos sanguíneos pequeños dentro del pulmón, lo que puede ocasionar neumonía eosinofílica y comprometer la función pulmonar.
La afectación cutánea también es frecuente y puede presentarse como lesiones vasculíticas, que son manchas o úlceras debido a la inflamación de los pequeños vasos sanguíneos en la piel. Estas lesiones pueden ser dolorosas y pueden ir acompañadas de petequias o púrpura, lo que indica un sangrado en la piel debido a la fragilidad de los vasos sanguíneos comprometidos.
Otro hallazgo relevante es la glomerulonefritis, que es una inflamación de los glomérulos renales, las unidades filtrantes del riñón. Esta condición puede llevar a insuficiencia renal si no se trata adecuadamente, ya que los glomérulos dañados no pueden filtrar los desechos del cuerpo de manera eficiente. La glomerulonefritis en GEP se puede presentar con proteínas en la orina, hematuria y disminución de la función renal.
La neuropatía vasculítica es otro aspecto clave de la GEP y se refiere a la inflamación de los nervios periféricos debido al daño de los vasos sanguíneos que los nutren. Esto puede resultar en dolor, debilidad, y pérdida de la sensibilidad en las extremidades, afectando gravemente la calidad de vida de los pacientes.
En cuanto al sistema cardiovascular, la miocarditis, que es la inflamación del músculo cardíaco, puede presentarse en los pacientes con GEP. La miocarditis puede dar lugar a arritmias cardíacas y, si no se trata de manera adecuada, puede progresar hacia insuficiencia cardíaca, una condición potencialmente fatal. El tratamiento temprano de la miocarditis es esencial para prevenir complicaciones graves, y puede incluir el uso de medicamentos inmunosupresores para reducir la inflamación.
Exámenes diagnósticos
El diagnóstico de la granulomatosis eosinofílica con poliangeítis debe ser considerado principalmente en aquellos pacientes que presentan eosinofilia periférica inexplicada y manifestaciones de vasculitis. La eosinofilia periférica es una elevación anormal del número de eosinófilos en la sangre, y puede estar asociada con diversas condiciones, incluida la granulomatosis eosinofílica con poliangeítis. Sin embargo, para confirmar el diagnóstico, es necesario llevar a cabo una serie de pruebas de laboratorio y de imagen que permitan no solo identificar la presencia de la eosinofilia, sino también descartar otras patologías con presentaciones similares.
El trabajo diagnóstico inicial debe incluir pruebas para la detección de anticuerpos anticitoplasma de neutrófilos (ANCA), particularmente los dirigidos contra la mieloperoxidasa (anti-MPO), ya que estos autoanticuerpos son comúnmente elevados en pacientes con granulomatosis eosinofílica con poliangeítis. Aunque no todos los pacientes con esta condición presentan ANCA, la detección de estos anticuerpos puede ser un indicio útil para orientar el diagnóstico. Además de las pruebas de ANCA, es recomendable medir los niveles de triptasa sérica, un marcador que puede estar elevado en enfermedades que involucran una activación excesiva de mastocitos, como en la leucemia eosinofílica, una enfermedad que también debe considerarse dentro del diagnóstico diferencial.
La citometría de flujo periférica es otra herramienta valiosa, ya que permite identificar anomalías en los receptores de factor de crecimiento derivado de plaquetas (PDGF, por sus siglas en inglés), alteraciones que pueden encontrarse en la leucemia eosinofílica, lo que ayuda a excluir esta condición como posible diagnóstico. Además, en algunas situaciones es fundamental realizar pruebas para infecciones helmínticas, dado que ciertos parásitos pueden inducir eosinofilia periférica como parte de su respuesta inmunológica. Las infecciones por helmintos, aunque raras en regiones con condiciones de salud adecuadas, pueden generar signos clínicos similares a los de la granulomatosis eosinofílica con poliangeítis.
En cuanto a las muestras de tejido obtenidas por biopsia, los infiltrados eosinofílicos son un hallazgo diagnóstico relevante. Estos infiltrados en los tejidos sugieren fuertemente la presencia de granulomatosis eosinofílica con poliangeítis, especialmente si se acompañan de signos de vasculitis, como púrpura, que es la aparición de manchas rojas o moradas en la piel debido a la ruptura de pequeños vasos sanguíneos; glomerulonefritis, que se manifiesta como una inflamación de los glomérulos renales; úlceras vasculíticas, que son lesiones cutáneas causadas por la inflamación de los vasos sanguíneos pequeños; y mononeuritis múltiple, que implica la afectación de varios nervios periféricos, provocando debilidad, dolor o pérdida de la función en las áreas afectadas. La presencia de estos hallazgos clínicos en conjunto con eosinofilia periférica ayuda a confirmar el diagnóstico de esta vasculitis rara.
Tratamiento
El tratamiento de la granulomatosis eosinofílica con poliangeítis se centra en la supresión de la inflamación y la modulación de la respuesta inmune para prevenir el daño orgánico. Los corticosteroides, como la prednisona, siguen siendo la primera línea de tratamiento debido a su capacidad para reducir rápidamente la inflamación y controlar los síntomas agudos de la enfermedad. Estos fármacos, al inhibir la actividad de varias células del sistema inmune, son eficaces en el tratamiento de las formas leves a moderadas de la enfermedad.
En casos de enfermedad de leve a moderada, se pueden agregar medicamentos inmunosupresores como la azatioprina o el metotrexato, que ayudan a reducir la necesidad de corticosteroides y a controlar la actividad de la enfermedad a largo plazo. Estos fármacos inhiben la proliferación de células inmunitarias y, por lo tanto, contribuyen a la supresión de la inflamación.
Más recientemente, el mepolizumab, un inhibidor de la interleucina 5 (IL-5), ha sido aprobado por la Administración de Alimentos y Medicamentos de los Estados Unidos (FDA) para el tratamiento de la granulomatosis eosinofílica con poliangeítis. La interleucina 5 es una citocina clave en la activación y expansión de los eosinófilos, por lo que bloquear su acción ayuda a reducir la eosinofilia y la inflamación relacionada con la enfermedad. Aunque el mepolizumab ha mostrado eficacia en el tratamiento de formas leves a moderadas, no se ha estudiado de manera exhaustiva en pacientes con manifestaciones graves de vasculitis que amenazan la vida o los órganos.
Para las formas más graves de granulomatosis eosinofílica con poliangeítis, especialmente aquellas con afectación de órganos vitales como los pulmones, los riñones o el corazón, el tratamiento habitual incluye el uso de ciclofosfamida, un potente agente inmunosupresor que puede prevenir el daño irreversible en estos órganos. La ciclofosfamida se utiliza para suprimir la actividad del sistema inmunológico en situaciones de alta gravedad, dado su potente efecto sobre las células inmunitarias y su capacidad para reducir la inflamación sistémica.

Fuente y lecturas recomendadas:
- Grayson PC et al; DCVAS Study Group. 2022 American College of Rheumatology/European Alliance of Associations for Rheumatology classification criteria for eosinophilic granulomatosis with polyangiitis. Arthritis Rheumatol. 2022;74:386. [PMID: 35106968]
- Papadakis, M. A., McPhee, S. J., Rabow, M. W., & McQuaid, K. R. (Eds.). (2024). Diagnóstico clínico y tratamiento 2025. McGraw Hill.